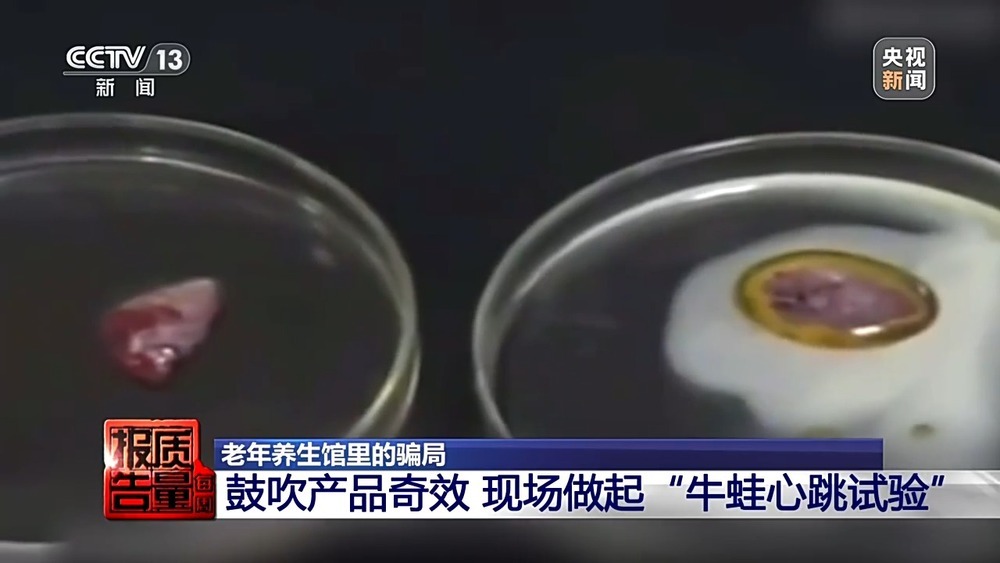
每周质量报告丨2万元床垫“包治百病” “神药”让牛蛙心跳不停?都是骗局! 每周质量报告丨2万元床垫“包治百病” “神药”让牛蛙心跳不停?都是骗局!

有这么一张神奇的床垫,推销人员声称“躺着就能保养身体”,不仅能消炎杀菌,还能治疗糖尿病、心脏病,把它买回去,相当于“把医院搬回了家”。
上海的王老伯在一家养生馆,就对这款神奇的保健床垫着了迷,当他亲眼看到使用床垫后病情好转的患者分享感受时,就毫不犹豫地付款2万多把床垫搬回了家。那么,王老伯这笔不小的花费究竟值不值呢?
前不久,上海市年近八旬的王老伯突然改变了原来的生活习惯,每天早上5点多,王老伯都要骑一个小时的电瓶车到浦东区的一个养生馆听讲座,一周六天雷打不动。不久后家人发现,王老伯花费2万多元将一款保健床垫买回了家。在王老伯眼中,这个床垫简直是能“包治百病”的宝贝。

消费者 王老伯:痔疮什么的都医得好,腔梗、脑梗全都好了。
王老伯的家人告诉记者,王老伯患有肺气肿、高血压和心脏病等慢性病,自从买了床垫之后,他甚至连医院都不肯去了。
消费者 王老伯:医院不去了。
记者:医院不去了?为什么?
消费者 王老伯:到医院里去,开刀要几十万元,这个床垫两万元,用一生一世。
什么样的保健床垫,能让收入不高的王老伯如此着魔,甘愿花费两万元购买?这种所谓的保健床垫真的如王老伯认为的那样能“包治百病”吗?记者来到了这家养生馆进行调查。

调查的几天时间里记者发现,这家生活保健馆从早上七点半到下午五点,每天都要举办十多场养生讲座,来参加的老人络绎不绝。
据销售人员介绍,除了能消炎杀菌,促进细胞生长,他们推出的这款床垫还能帮助清除血管中的毒素,能预防心脑血管疾病。
在推销人员口中,这款神奇床垫不仅具有保健功能,甚至能治疗糖尿病、心脏病等各种疾病。百余平方米的屋子里,台下几十位老人坐得满满当当,听得极为认真。

在这家养生馆除了听讲座,还允许听课的老人现场体验。记者在养生馆看到,四十多张床垫上躺满了老人。四十分钟一轮,一个上午就有几百人次。
记者注意到,这款被工作人员推销的神奇床垫,标价从19980元到21980元不等。虽然售价不菲,但像王老伯一样不惜斥巨资购买的老年人不在少数。

消费者:买了床垫后,我自己好了。
记者:你自己买了?那为什么还要来?
消费者:这里热闹。我不仅自己要买,而且我要和儿子说也睡一下。
记者注意到,这家养生馆里推销的保健床垫,全名叫“电位温热治疗仪”,是一种二类医疗器械,通电后可加热到30到60摄氏度,人体躺在上面具有温热感。其注册证中标注适用于:坐骨神经痛、风湿性关节炎、植物系统功能紊乱等疾病的 辅助治疗。根据我国相关规定,二类医疗器械具有严格的注册范围和限制,不得超范围宣传其疗效。
然而记者调查发现,部分养生馆、体验馆的销售人员在推销产品的过程中,大都宣称所谓保健床垫可以治疗糖尿病、心脏病等困扰老年人的疾病。

记者随后将调查情况反映给养生馆所在地的市场监管部门,在市场监管人员获取的养生馆监控视频里,记者看到,一位身着红色上衣的销售人员正在向老人们推销他们的保健床垫。
据这位销售人员介绍,一位曾患过六次脑梗的80多岁患者,因为持续使用他们的床垫,身体状况得到了显著改善。
销售人员言之凿凿,声称他们的床垫对脑梗患者有显著疗效。对此,老人们也是深信不疑。然而在调查中,市场监管人员向记者透露, 所谓患有六次脑梗的老人实际并不存在,是销售人员捏造的虚假信息。

上海市浦东新区市场监管局航头市场监管所 顾成章:病例肯定是虚构的,我们经过调查并没有这样一个病人,在课堂上说这个案例只是为了更好销售他们的床垫。
调查中记者发现,除了编造子虚乌有的病例打消老人的疑虑,为了诱使他们购买所谓的保健床垫,销售人员又上演了另一套把戏。

监控视频显示,在推销人员的指引下,有多位老人被戴上了大红花,登台接受所谓“表彰”。现场推销人员介绍,这些老人都是已经购买了床垫的顾客,其中一位老人还被邀请分享他使用保健床垫之后降血糖的成果。
据这位老人介绍,他坚持用保健床垫,血糖有了明显改善。然而记者在调查中了解到,这样的 成果分享并不属实。

上海市浦东新区市场监管局航头市场监管所 顾成章:他并没有真正购买这个床垫 ,他其实是养生馆请的一个演员,床垫没有治疗血糖、降血糖的能力,这是一个虚假宣传行为。
在市场监管人员获取的该保健床垫的宣传材料中,记者看到,这款保健床垫被宣称为“是渴望健康和幸福人的必需品”,一旦床垫买回家就相当于“在家里开了综合医院”,覆盖“内科,外科,耳鼻喉,泌尿,妇科,皮肤科等”各个科室。 这样的宣传语极具诱惑性,缺乏辨识能力的老年人往往容易轻信。

上海市浦东新区市场监管局航头市场监管所 许姚:他们通过这种宣传给老人造成了一种误解,让老年人深信不疑认为他们的产品确实是有治疗功效的,可以达到治疗高血压、肺癌或者是糖尿病这些疾病的功能,让老年人最后掏出了自己口袋里的钱,购买了他的产品。
市场监管人员表示,作为二类医疗器械,类似的保健床垫仅适用于肩周炎、坐骨神经痛等疾病的辅助治疗,销售过程中不得宣称具有疾病治疗功效。

据了解,在不到两年时间里,该养生馆通过虚假宣传共计售出保健床垫153台,销售额三百余万元,盈利一百余万元。
最终,市场监管部门对涉案企业罚款50万元,责令其停止违法行为,限期整改。
积分返现诱惑 前后花掉7万余元
想要健康、想要治病,很多老人因此被精心设计的虚假宣传迷了双眼,面对几千元几万元的保健品毫不吝惜。但是也有一部分消费者在掏钱的那一刻保持了谨慎和警惕。湖北的陈大妈就是这样,第一次没买,第二次也没掏钱,但是第三次,她却在销售人员“积分返现”的套路中放松了警惕,前前后后花出去7万多元。

陈大妈家住湖北十堰房县,老伴因患有心脏疾病,常年需要用药维持。这两年,随着年龄的增长,老伴的身体每况愈下,这让陈大妈很是着急。前段时间,陈大妈被邻居拉去参加了一家养生馆办的健康讲座。那里的讲师告诉陈大妈,他们这里有一种胎盘胶囊,对她老伴的心脏病有奇效,劝她买回家试试。
据陈大妈回忆,为了让老人们相信他们的产品能治心脏病,养生馆的讲师在现场还进行了所谓的牛蛙心跳试验——讲师将两颗解剖后的活体牛蛙心脏取出后,分别放在两个容器中,然后向其中一个容器滴入所谓含有保健品成分的试剂,未滴入试剂的牛蛙心脏不久后便停止了跳动,而滴过试剂的牛蛙心脏仍能维持心跳。
在场的老年人都被实验效果所吸引,讲师借此开始鼓吹这款产品对心脏治疗的奇效,当时在现场的陈大妈听得也动了心,但胎盘胶囊一盒近三千元的价格还是让她陷入了犹豫。
陈大妈告诉记者,面对她的犹豫不决,讲师表示,除了胎盘胶囊,他们养生馆里还有很多其他好产品。如果加入会员,定期参加活动购买产品,还能积分,也能返现。
就这样,在讲师的一再劝说和入会返现的诱惑下,陈大妈最终成了养生馆的会员。
记者:最后他说给你返多少钱?一共去了几次?
消费者 陈大妈:他说每次一个星期返600元。一共去了三四次,前前后后有七八万元。

成为会员之后,为了多攒积分,早日返现,陈大妈先后在这家养生馆购买了胎盘胶囊、灵芝孢子粉、人参皂苷胶囊、羊奶粉等多种产品,累计花费7万余元。然而产品买回了家, 老伴儿换着花样不停地吃,身体状况却没有任何改善。
消费者 付老伯:一点儿效果都没有,还是治病的药有效果,别的没一点儿效果。
对于陈大妈来说,7万元不是一笔小数目。让她没想到的是,花光了这7万元之后,不仅老伴的身体没有好转,养生馆之前承诺的积分返现也不兑现了。直到民警找上门来,陈大妈才如梦初醒,意识到自己上当了。

消费者 陈大妈:后来说返钱,钱也返不到了。当时我想真好,又返钱,还给我们奖品,还给保健食品吃。哪想到受了人家的骗,一分钱都没拿到,钱到人家手里去了,我们兜里都掏干净了。

湖北省十堰市房县公安局刑事侦查大队民警 李永能:他们通过向老年人发放小礼品,鸡蛋、面条等,从而达到获客目的。他们会对接专门的讲师过来讲课,做一些试验,放一些宣传视频,证明他们所销售的保健品的功效。
记者了解到,在健康讲座现场,让老人们目瞪口呆的所谓牛蛙心跳试验,实际只是一种故弄玄虚的骗人手段。
湖北省十堰市房县公安局刑事侦查大队民警 李永能:牛蛙的心脏和人的心脏结构上不同,牛蛙的心脏取出来之后,它还可以持续跳两个小时,滴一点生理盐水后,它的跳动幅度和频率都会增加。犯罪分子就是利用了这样一个可能老百姓不懂的常识,就谎称所滴的试剂是他们所售卖的保健品研磨出来的,滴在上面,使心脏又重新焕发了活力。

调查中记者了解到,讲师向陈大妈推荐的所谓胎盘胶囊,也并不是什么能预防心脏病的“神药”,仅为一种保健食品,全名标称为“益普利生牌羊胎盘维E软胶囊”,保健功能为增强免疫力。
记者注意到,这个养生馆每半个月组织一次健康讲座和推销活动,每次推销的保健品均不同,包括灵芝孢子粉、羊胎盘胶囊等各类产品,但是记者在调查中发现,这家养生馆卖给老年人的 各种保健品,全都是从山东一个生产厂家订购而来,出厂价仅为十几元一盒。该养生馆把同样的原料,换上不同的包装,向老年人鼓吹这些产品具有修复细胞、提升营养、治疗各类疾病等疗效,同时,以购买产品能返现等套路,欺骗老年人购买。要价动辄高达几千元, 利润可达几十倍。

湖北省十堰市房县公安局刑事侦查大队民警 李永能:我们追溯到源头生产厂家,发现保健品不加包装的话就十几块钱出厂价,包装盒又找其他负责包装的地方,相当于是个性化生产,包括产品名还有包装瓶子的设计都是养生馆出方案,之后人家给他生产包装。
最终,涉事养生馆三名犯罪嫌疑人因犯诈骗罪分别被判刑。

近年来,以治疗疾病和养生保健为幌子,通过夸大产品疗效、虚假宣传、情感营销等手段诱骗老年人购买所谓保健品的骗局屡见不鲜。记者在中国裁判文书网以保健品虚假宣传为关键词进行搜索,共计找到2144篇法律文书。梳理这些案件记者发现,涉老年人保健品诈骗案件呈现逐年上升趋势,而这类案件的诈骗手段都很相似。
江苏省南京市栖霞区人民法院刑事审判庭庭长 赵丽:犯罪分子往往通过送小礼品、免费体检等方式给予老年人温情关怀,让老年人放下戒心,取得老年人信任后,紧盯老年人需求痛点,以养老产品养老项目等名义实施诈骗。

大量的保健品诈骗案件利用老年人注重养生和健康的心态,散布各类健康谣言,贩卖焦虑,随后将出厂价特别低的一些保健品,包装成可以包治百病的灵丹妙药,加价数倍,诱骗老年人购买。

上海市浦东新区市场监管局航头市场监管所副所长 陈灵炯:老年人应当警惕严重夸大其词虚假宣传的广告,尤其是那些宣称具有治疗各种疾病功能的产品,老年人应当保持警惕,如果有必要可以向有关部门进行反映或者寻求帮助。
大量针对老年人特别是独居老人的保健品骗局,营销人员常常利用“关怀”的幌子,嘘寒问暖,建立信任,一步步把话题引导到疾病、健康,最后诱导老人高价购买保健品。
保护老年消费者,让他们免受伤害,有关部门要加强监督,严厉打击虚假宣传、非法销售等行为。子女也要多关心老人的生活和心理需求,让他们不再被骗子的“情感牌”和“圈套”所迷惑。
记者丨高杰 吴睿 吴骥 黎亚东
点击右上角
微信好友
朋友圈

点击浏览器下方“
”分享微信好友Safari浏览器请点击“
”按钮

点击右上角
QQ

点击浏览器下方“
”分享QQ好友Safari浏览器请点击“
”按钮
